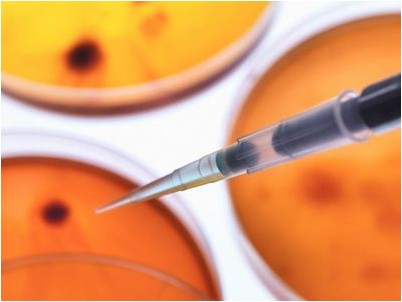
имел возможность

Как люди, жующие на сэндвичах, сделанных из Индеек в День благодарения, основанные на животе микробы хлебают оставшиеся питательные вещества. Новое изучение у мышей говорит о том, что бактерии, вызывающие язвы, устанавливают колонии в животах посредством водородного газа, произведенного дальше вперед в пищеварительном тракте.
Работа, сообщил в выпуске 29 ноября Науки, показывает в первый раз, что жуки имеют вкус к водороду, и это предлагает новые методы руководить вызывающими страдание существами.Хеликобактер пилори приводит 90% к язвам желудка.
Бактерия живет нормально во многих животах, пока она по некоей малоизвестной причине не приводит к болезненным язвам. Вторая тайна – то, как H. pylori существует в пищеварительном тракте. Биолог Роберт Майер из Университета Джорджии в Афинах и сотрудников ранее нашёл фермент в микроорганизме, разрешающем ему питаться водородным газом, и маленькие количества горючего, как показывалось, просочились из двоеточия грызунов и людей.
Заинтригованный, они удостоверились в надежности, имел возможность ли газ, плывший назад к животу, активизировать фермент.Для определения важности фермента к свойству бактерий открыть магазин в животе бригада отключила фермент в одном напряжении микроорганизма. Они ввели это нормальное напряжение и напряжение в животы мыши и учитывались какое количество колоний бактерии организованный после 4 недель.
Без способности потягивать водород, бактерии установили на 75% меньше колоний, указав важную роль для фермента. Майер говорит, что у других инфекционных бактерий, таких как сальмонелла имеется фермент. «Водород имел возможность бы играть роль в подготовке нехорошего [инфекции]», говорит он.
Понимание окажет помощь в поиске способов бороться с инфекционными бактериями, говорит биолог Франк Гэрардини из Горной Лаборатории Рокки в Гамильтоне, Монтана. «Сейчас мы можем предназначаться для определенного фермента». Микробовый эколог Джон Брезнэк из Университета штата Мичиган, Ист-Лэнзинг, именует работу «добрым открытием» и предлагает диетическое изменение, «минимизирующее, сколько водородного газа добирается до живота», имел возможность бы руководить вызывающим язву жуком.